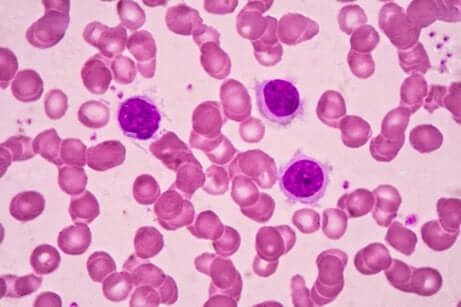

Qu'est-ce que le myélome multiple ?


Rédigé et vérifié par le médecin Leonardo Biolatto
Le myélome multiple est une pathologie oncologique, c’est-à-dire un cancer de l’être humain. Il naît dans la moelle osseuse, qui est le tissu formant les cellules sanguines qui circuleront ensuite à travers tout l’organisme.
La moelle osseuse se trouve dans les os du corps et, à partir de là, crée des cellules qui se déplacent vers le tissu hématique. Parmi ces cellules, une variété sont les cellules plasmatiques, qui sont responsables du myélome multiple en se multipliant anormalement et excessivement.
Dans des conditions normales, les cellules plasmatiques ont pour fonction de combattre les infections. Elles accomplissent cette tâche à travers la production de substances connues sous le nom d’anticorps. Les anticorps reconnaissent les agents infectieux qui essayent de rendre l’être humain malade et les attaquent.
Avec le myélome multiple, étant donné qu’il existe une quantité anormale de cellules plasmatiques, il y a aussi une production anormale d’anticorps. Cela ne génère pas de plus grandes défenses mais favorise les infections et les complications qui en dérivent.
Facteurs de risque du myélome multiple
Comme l’indique la littérature scientifique, il existe une série de facteurs qui font augmenter la possibilité de souffrir de myélome multiple. C’est le cas de :
- Âge : plus l’âge est avancé, plus les possibilités de souffrir de ce cancer sont élevées. Les personnes de plus de 65 ans sont les plus affectées.
- Antécédents familiaux : il existe des familles avec une certaine prédisposition pour cette maladie. Ce n’est pas un facteur déterminant, mais le fait d’avoir un parents ou un frère/une sœur avec cette maladie augmente le risque d’en souffrir.
- Être un homme : le sexe masculin a une plus grande prévalence de ce cancer que les femmes.
- Être d’origine afro-américaine : les Afro-américains sont un groupe avec un plus grand risque de présenter un myélome multiple que le reste de la population.
Le myélome multiple est un cancer du sang, le second plus fréquent de ce type.
Poursuivez votre lecture : Le lymphome, un cancer silencieux qui peut être traité avec succès s’il est détecté à temps
Symptômes du cancer
Le diagnostic du myélome multiple est parfois retardé à cause des symptômes non spécifiques. Il s’agit d’une pathologie au cours de laquelle la majorité des signes peuvent être confondus avec d’autres maladies. Si le médecin n’a pas de soupçons clairs, ou ne détecte pas quelque chose d’inhabituel avec les méthodes complémentaires, un retard dans le diagnostic est possible.
Parmi les symptômes les plus communs, nous avons :
- Douleur osseuse : prioritairement dans les os du tronc du corps, du thorax et du dos.
- Changements gastro-intestinaux : cela inclut les vomissements et la constipation.
- Inappétence : l’absence d’appétit, si elle dure dans le temps, entraîne une perte de poids avec amaigrissement.
- Infections à répétition : les défenses affaiblies, comme nous l’expliquions, favorisent l’entrée de micro-organismes qui génèrent des infections. Ces micro-organismes peuvent produire des infections communes qui ne se résolvent pas rapidement.
Diagnostic du myélome multiple
La première étape pour procéder au diagnostic du myélome multiple consiste à le soupçonner. Ceci est très difficile à cause des symptômes non spécifiques de la maladie. Par ailleurs, il peut arriver que les résultats d’un laboratoire demandés pour autre chose orientent les soupçons du médecin.
Le test de laboratoire par excellence est la recherche de l’anticorps monoclonal. Il s’agit d’une protéine anormale qui porte le nom de Protéine M et qui, si elle apparaît, indique un myélome multiple.
La seconde étape dans ce processus de diagnostic est la biopsie de la moelle osseuse. Il s’agit de prélever une portion de la moelle osseuse, en l’aspirant depuis l’intérieur d’un os pour examiner ce tissu au microscope. Ainsi, il est possible de voir en premier plan dans quelles conditions se trouvent les cellules plasmatiques.
On réalise également à l’échantillon prélevé :
- Cytogénétique : il s’agit d’une analyse sur l’ADN des cellules aspirées.
- Immunohistochimie : pour différencier les cellules normales des anormales.
- Cytométrie en flux : afin de déterminer si les cellules anormales sont d’un myélome multiple ou d’un autre cancer sanguin comme le lymphome.

On parvient au diagnostic définitif de myélome multiple à travers une biopsie de la moelle osseuse.
Lisez aussi : Qu’est-ce qu’une biopsie liquide ?
Traitement pour le myélome multiple
Le traitement du myélome multiple requiert une approche multidisciplinaire au cours de laquelle différents spécialistes interviennent. L’équipe oncologique qui traite ces patients inclut des hématologues et, dans la mesure du possible, des hématologues avec une expérience dans cette maladie oncologique.
La radiothérapie est l’une des options thérapeutiques. Le myélome multiple est sensible à la radiation médicale, ce qui peut réduire la portée de la maladie et également contrôler la douleur osseuse qui se crée à partir de la maladie.
La chimiothérapie est indiquée pour les personnes chez qui le myélome multiple a progressé. Malheureusement, les taux de survie chez les patients soumis à une chimiothérapie sont faibles. On calcule qu’au bout de cinq ans, le nombre de survivants est de moins d’un tiers.
Enfin, un traitement qui est très efficace et qui est soutenu par un grand nombre d’études scientifiques est la transplantation. Dans ce cas, on utilise l’auto-transplantation de moelle osseuse.
Que ne devons-nous pas oublier sur cette maladie ?
Le myélome multiple est une maladie grave. Comme tout cancer, il requiert un diagnostic opportun pour améliorer les possibilités de survie. Par conséquent, si vous avez des symptômes qui vous font penser à cette maladie, ou des antécédents familiaux de cette maladie, il vaut mieux consulter un médecin et se débarrasser de ces doutes.
En cas de soupçons, les professionnels de santé peuvent guider le processus de diagnostic pour réaliser les examens nécessaires à chaque instant. Et si l’on souffre effectivement d’un myélome, il faut appliquer le meilleur traitement disponible, qui est continuellement étudié et révisé.
Toutes les sources citées ont été examinées en profondeur par notre équipe pour garantir leur qualité, leur fiabilité, leur actualité et leur validité. La bibliographie de cet article a été considérée comme fiable et précise sur le plan académique ou scientifique
- García-Sanz, Ramón, María Victoria Mateos, and Jesús Fernando San Miguel. “Mieloma múltiple.” Medicina Clínica 129.3 (2007): 104-115.
- Díaz-Maqueo, José C. “Historia del mieloma múltiple.” Revista Biomédica 17.3 (2006): 225-229.
- Charlot-Lambrecht, I., et al. “Mieloma múltiple.” EMC-Aparato locomotor 45.1 (2012): 1-13.
Ce texte est fourni à des fins d'information uniquement et ne remplace pas la consultation d'un professionnel. En cas de doute, consultez votre spécialiste.